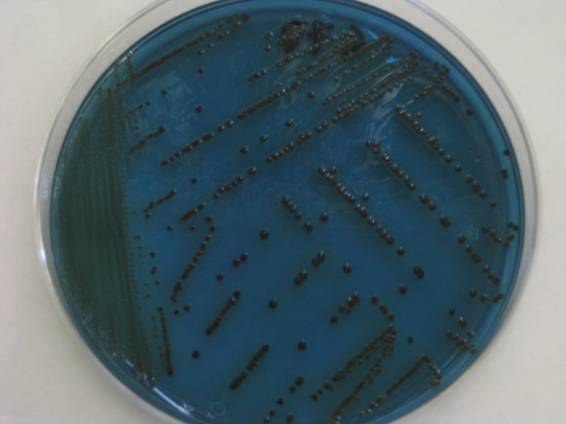

Clutch, Venom, Confidor, Talstar, Actara y Engeo fueron los insecticidas evaluados para combatir el insecto-plaga de los cítricos
Clutch, Venom, Confidor, Talstar, Actara y Engeo fueron los insecticidas evaluados para combatir el insecto-plaga de los cítricos
De acuerdo con el proyecto Fluctuación poblacional de Diaphorina citri Kuwayama e insecticidas biorracionales para su control en cítricos en Sinaloa, que Fundación Produce Sinaloa, A.C., apoya a través de su Consejo Consultivo zona norte, durante el ciclo 2010-2011, se transmitirán a productores y asesores técnicos este 19 y 20 de mayo, los resultados de la última evaluación sobre la efectividad biológica de insecticidas que pueden utilizar en sus huertos. Estos resultados se presentarán en Sinaloa de Leyva y La Guamuchilera, Sinaloa, a través de un día demostrativo.
Comúnmente, se requieren alrededor de cinco aspersiones de insecticidas por hectárea al año, para el control de D. citri, con un costo alrededor de 2 mil 500 pesos. Con el empleo de insecticidas novedosos, el número de aspersiones de insecticidas requeridas será menor, por lo que la relación B/C se podría incrementar, además de que se reduce el riesgo de que el insecto transmita el HLB.
Se determinó la efectividad biológica de insecticidas sobre ninfas de Diaphorina citri
A través de este proyecto, se ha documentado información sobre la bioecología del insecto vector con relación a la fenología (cambio de apariencia que sufren las plantas durante las estaciones) de especies de cítricos y se ha determinado la efectividad biológica de insecticidas sintéticos convencionales y con diferente modo de acción, seleccionando productos que causaron mortalidad de 85 por ciento o mayor.
El insecticida Clutch, tres días después de la aplicación, mostró la mayor mortalidad de ninfas pequeñas, sin diferenciarse estadísticamente de Venom, Confidor, Talstar, Actara y Engeo, con mortalidades del 89 por ciento hasta 100 por ciento.
Respecto a ninfas grandes, el Confidor mostró la mayor mortalidad (90.4 por ciento), sin diferenciarse estadísticamente del Venom, Talstar y Engeo.
Siete días después de la aplicación de los insecticidas evaluados, Talstar, Actara, Engeo, Clutch Venom, Confidor y Movento mostraron un porcentaje de mortalidad de ninfas pequeñas cercana a 100 por ciento.
Para ninfas grandes sólo Movento mostró elevada efectividad (96.8 por ciento).
Exalt mostró la menor efectividad sobre el insecto en los dos estados de desarrollo considerados en ambas lecturas de mortalidad.
El estudio sobre la naranja (Citrus sinensis) se realizó en la huerta ?Citrípolis?, ubicada en el valle de Culiacán. Al momento de la aspersión predominaba la etapa de ninfa del psílido asiático de los cítricos.
La producción de cítricos en Sinaloa, una alternativa para el desarrollo alimentario y económico
Sinaloa posee infraestructura adecuada para la explotación y está cercano al mercado estadounidense, principal importador de cítricos del Brasil y de México, además de que cuenta con condiciones agroecológicas aptas para el desarrollo de una citricultura diversificada (naranjas, mandarinas, limas, limones, toronjas y clementinas), características que lo ponen en ventaja respecto a la mayoría de los estados de la República Mexicana.
Por lo anterior, las acciones encaminadas a generar tecnología para cultivos cítricos en el estado son de gran importancia para los productores agrícolas. Sobre todo en este caso, en el que se realizan estudios acerca de un insecto-plaga que puede provocar que la actividad citrícola sufra siniestros incalculables.
Cuadro. Insecticidas, Ingredientes activos, clase química y dosis de insecticidas evaluados contra D. citri en naranja.

Información proporcionada por Edgardo Cortez Mondaca, responsable del proyecto, perteneciente al Instituto Nacional de Investigaciones Forestales, Agrícolas y Pecuarias (INIFAP).


 Con este método se incrementa la producción de sorgo, se conserva mejor la humedad del suelo en zonas de temporal y se obtienen mayores beneficios económicos
Con este método se incrementa la producción de sorgo, se conserva mejor la humedad del suelo en zonas de temporal y se obtienen mayores beneficios económicos
 El ex presidente Ejecutivo de Fundación Produce Sinaloa (FPS) A.C., confía en que de manera conjunta se mejorarán condiciones de vida y se crearán más empleos
El ex presidente Ejecutivo de Fundación Produce Sinaloa (FPS) A.C., confía en que de manera conjunta se mejorarán condiciones de vida y se crearán más empleos ¿Puede la presencia de microorganismos patógenos alcanzar la superficie de frutos frescos utilizando el agua como medio de transporte?
¿Puede la presencia de microorganismos patógenos alcanzar la superficie de frutos frescos utilizando el agua como medio de transporte? Se presentan variedades chile habanero, aptas para la región, desarrolladas bajo condiciones de casa sombra
Se presentan variedades chile habanero, aptas para la región, desarrolladas bajo condiciones de casa sombra
 El proyecto, iniciado en 2009, se consolida brindando capacitación para que los productores sinaloenses puedan ofrecer una variedad más amplia de productos lácteos a los consumidores
El proyecto, iniciado en 2009, se consolida brindando capacitación para que los productores sinaloenses puedan ofrecer una variedad más amplia de productos lácteos a los consumidores La Fundación brinda información sobre elaboración de productos, validación de cultivos alternativos y transferencia de tecnología
La Fundación brinda información sobre elaboración de productos, validación de cultivos alternativos y transferencia de tecnología